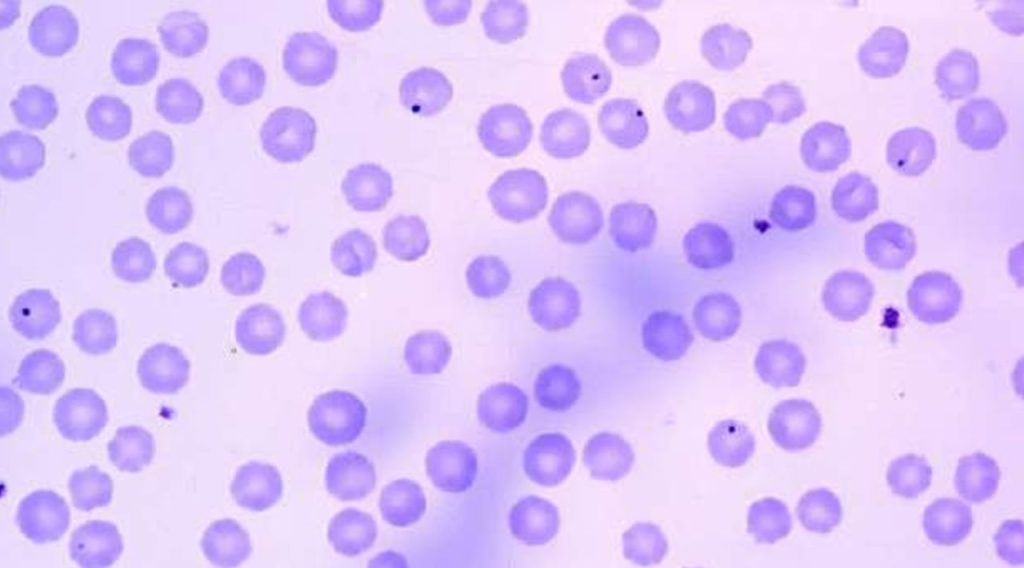

Las garrapatas son parásitos conocidos desde hace miles de años, pero las enfermedades que transmiten se documentaron hasta el siglo XX. Con el desarrollo de métodos diagnósticos más precisos y mayor conciencia sobre las enfermedades transmitidas por vectores, se ha mejorado su manejo clínico1. Aun así, estas enfermedades continúan siendo infradiagnosticadas. En el caso de la anaplasmosis y la ehrlichiosis, los síntomas inespecíficos dificultan su distinción. Conocer la distribución geográfica de las garrapatas, su ciclo de vida y los patógenos que transmiten ayuda a orientar el diagnóstico y tratamiento2.
La ehrlichiosis monocítica humana (EMH) se describió en 19873 y la anaplasmosis granulocítica humana (AGH) humana en 19944. Inicialmente, se pensó que ambas pertenecían al mismo grupo5, pero en 2001 se reclasificaron como dos especies distintas: Ehrlichia chaffeensis y Anaplasma phagocytophilum6,5.
Figura 1. Trama de la transmisión de A. phagocytophilum y E. chaffeensis entre sus reservorios, vectores, el hombre como hospedero accidental y las células blanco de la infección. Figura: Elaboración propia; Micrografías: Stephen Dumler (izquierda-neutrófilo); Bobbi Pritt (derecha-macrófago).

Transmisión y epidemiología
A. phagocytophilum y E. chaffeensis se transmiten por la mordedura de garrapatas infectadas5, que introducen la bacteria al hospedero durante su alimentación7. También se ha documentado transmisión por transfusión sanguínea, vía hospitalaria y transplacentaria en anaplasmosis7, así como casos por trasplante de órganos en la EMH8.
La AGH ocurre en Europa, Asia y América del Norte8, con un aumento de casos de 348 en 2000 a 5,655 en 20196. La vigilancia ha registrado tasas superiores a 50 casos por cada 100,000 habitantes3. La ehrlichiosis predomina en Estados Unidos, con tasas de 100-200 casos por cada 100,000 habitantes en zonas endémicas3,8. En 2020, el CDC reportó 3,637 casos de anaplasmosis y 1,178 por infección con E. chaffeensis en este país9. Siendo los principales grupos de riesgo personas inmunocomprometidas y de edad avanzada10,5.
Patogénesis y cuadro clínico
A. phagocytophilum provoca inflamación intensa, con aumento de neutrófilos y otros componentes que dañan órganos y favorecen la diseminación6,8. En cambio, E. chaffeensis causa inmunosupresión por pérdida masiva de células inmunológicas, lo que facilita las infecciones oportunistas8,11.
Ambas enfermedades provocan síntomas similares: fiebre, dolor de cabeza, malestar, dolor muscular y articular. También pueden disminuir los glóbulos blancos y plaquetas y aumentar enzimas del hígado8,12. La mayoría de los casos son leves o moderados, pero en personas con factores de riesgo o tratamiento tardío pueden surgir complicaciones graves como sepsis, daño pulmonar, renal y falla de órganos5,10.
En la anaplasmosis, las erupciones en la piel son poco comunes (menos del 10%)10,12, y pueden presentarse náuseas, vómitos o diarrea11. En la ehrlichiosis, las erupciones son más frecuentes, junto con daño al hígado, disminución de plaquetas y complicaciones neurológicas en hasta el 20% de los casos10,12.

Métodos diagnósticos
El diagnóstico se basa principalmente en los síntomas, ya que durante las primeras dos semanas las pruebas no siempre están disponibles. En la etapa aguda, la prueba más recomendada es la PCR en sangre total, que detecta directamente el material genético de las bacterias, con una especificidad del
60–85% y sensibilidad del 67–90% para A. phagocytophilum y 60–86% para E. chaffeensis6. Otras pruebas, como las serológicas o frotis sanguíneo, pueden apoyar el diagnóstico, aunque son menos sensibles y específicas3,5,7.
El cultivo es el método diagnóstico más confiable, pero puede tardar semanas y solo está disponible en laboratorios especializados6,12. Ya que el diagnóstico temprano es clave para evitar complicaciones, se recomienda iniciar tratamiento sin esperar los resultados de laboratorio5.

Medidas de prevención
No existen vacunas para estas enfermedades, por lo que la mejor prevención es evitar la mordedura de garrapatas7. Se recomienda usar ropa clara que facilite su detección, aplicar repelentes con N,N-dietil-meta-toluamida (DEET) y revisar cuidadosamente el cuerpo y la ropa tras estar en zonas de riesgo. Como la transmisión ocurre entre 4 y 24 horas después de la mordedura, retirarlas a tiempo es clave para prevenir la infección3.
Conclusión
La anaplasmosis y la ehrlichiosis son enfermedades emergentes que afectan la salud humana. Aunque comparten síntomas y formas de transmisión, difieren en su agente causal y algunas manifestaciones clínicas. El diagnóstico temprano mediante PCR y el tratamiento oportuno son clave para reducir complicaciones. Su aumento en los últimos años resalta la necesidad de conocerlas mejor y promover medidas de prevención en zonas con presencia de garrapatas.